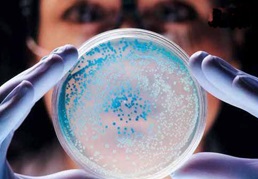

欧洲科学家发现新型抗菌活性化合物
最近,欧洲科学家从一种生长在马粪堆里的常见蘑菇中分离得到了一种具有抗菌活性的新型化合物,研究表明它与传统抗生素具有相同的抗菌作用,不同的是该化合物是一种活性蛋白质。长久以来,人们一直都认为抗生素能够治愈细菌性疾病,然而细菌耐药性的频繁出现逐渐在动摇这一认识,全球人口不断面临着新的健康威胁。当前,世界各地的生化学家都在进行着一场与时间赛跑的比赛,希望能够开发出一系列新型抗生素来取代目前日益低效的传统抗生素,早日解决越来越棘手的细菌耐药性问题。或许,Copsin的发现有可能就是一种极具潜力的解决方案。
最早开始时,该研究团队正着手于探究真菌和周围各种各样细菌之间相互生长的影响关系,他们无意中发现生长在马粪里的一种常见墨汁鬼伞蘑菇Coprinopsis能够产生具有抗菌作用的活性化合物。通过进一步的研究确认原来马粪的基质是产生这种活性化合物的关键。具体来讲,马粪是一种营养非常丰富的天然基质,孕育了多种多样的微生物,其中包括了真菌和细菌。这些微生物在营养和生长空间上存在着持续不断的竞争关系,因此这种环境容易产生新的具有抗菌活性的物质。
随后,研究人员收集了马粪,从中进行分离并且最终确定由墨汁鬼伞蘑菇产生的Copsin 正是这种起到抗菌作用的活性化合物。进一步的研究表明,Copsin 通过与细菌细胞壁形成的一个必需结构单元相结合从而破坏了细胞壁的合成最终杀死细菌。细胞壁可以看作是细菌的阿喀琉斯之踵,因此当细菌细胞壁的合成受到破坏之后,通常细菌都会迅速死亡。值得注意的是,与以往的许多破坏细菌细胞壁合成的抗生素不同,Copsin与细菌细胞壁必需结构单元之间的结合方式是非常独特的,这种独特的结合方式使得Copsin具备了对抗细菌耐药性的生物活性。从化学成分的角度来看,Copsin是一种类似于"防御素"的蛋白质,而传统的抗生素往往都是非蛋白质类的小分子化合物。通常,人体本身也会在自身的皮肤和黏膜组织中产生某些防御素来保护自己免受感染。
随着研究的深入,研究人员发现毕赤酵母的代谢产物中也含有Copsin。为了获取更多的Copsin,他们目前正在使用能够提供可控条件和无菌环境的生物反应器,通过加入液体培养基进行毕赤酵母的发酵,然后经过纯化分离最终获得Copsin。整个过程相对比较漫长,毕赤酵母的培养需要5天的时间,之后才可以收集细胞进行分离纯化步骤。
值得一提的是,Copsin是一种非常稳定的蛋白质,能够耐受100摄氏度的高温以及强酸性环境,甚至在经过一些酶的处理之后仍然能够保持活性。此外,Copsin可以杀死多种病原菌,例如能够导致严重食品中毒的李斯特菌。上述这些特性使得其未来的应用前景极为广泛,诸如在制药工业、食品工业以及产品涉及到高温和强酸环境的一些领域。
需要特别说明的是,到目前为止,Copsin是否能够在实际应用中取代传统抗生素作为一种新的抗生素来使用,这一点还有待于进一步的研究,尤其是Copsin对人体安全性方面的考量。尽管如此,一个简单却有趣的事实却值得我们深思,特别是对于那些致力于寻找新型抗生素的科学家们,那就是大自然中的真菌利用防御素以及其他天然的抗生素基质在数以百万年的时间里来成功地保护自身免受各种细菌的侵害,而人类作为治病救人的抗生素仅仅在使用了短短的70年之后就产生了严重的细菌耐药性问题。或许,我们可以把目光转移到真菌身上,从中去找到一些答案。
![]() |
![]() |
![]() |
官网:www.cxbio.com | 微信服务号:iseebio | 微博:seebiobiotech |
![]() |
![]() |
![]() |
商城:mall.seebio.cn | 微信订阅号:seebiotech | 泉养堂:www.canmedo.com |
相关资讯
- 我国首批转基因克隆牛成功繁育后代
- Cell:深入认识诱导性多能干细胞产生过程
- Heteroglycan 杂多糖 - Elicityl生物质提取天然多糖和寡糖产品(14)
- Nature:糖尿病增加患癌风险的分子机制揭开
- Blood:利用CRISPR-Cas12a基因编辑有望治疗β-地中海贫血
- 冷冻治疗糖尿病已见曙光
- 感染新冠竟丧失嗅觉和味觉?Nature子刊揭示基因变异或是罪魁祸首
- 2017年10月西宝生物员工生日会
- 西宝生物 - 发明专利证书 编号:4803222
- Nat Commun:突破!科学家成功阐明糖分和癌症发生之间的分子关联
新进产品
同类文章排行
- 清除人体内衣原体感染的关键钥匙
- iScience:一种对抗遗传性神经系统疾病的潜在途径
- 真的有可以中和所有已知COVID-19毒株的抗体?
- 细胞“废物”使抗癌的免疫细胞恢复活力!
- 男性注意!这种食品摄入过多会导致结直肠癌
- 无路可退!主食中的农药残留,可诱发阿尔茨海默病
- Cell出乎意料新发现:原来是这种“濒死体验”让癌细胞恶化
- 研究发现,冠状病毒的形状会影响其传播
- Science Advances新突破:快速高效生产人体免疫细胞的新方法
- 《Nature Genetics》确定10个克罗恩病相关基因
资讯文章
您的浏览历史
